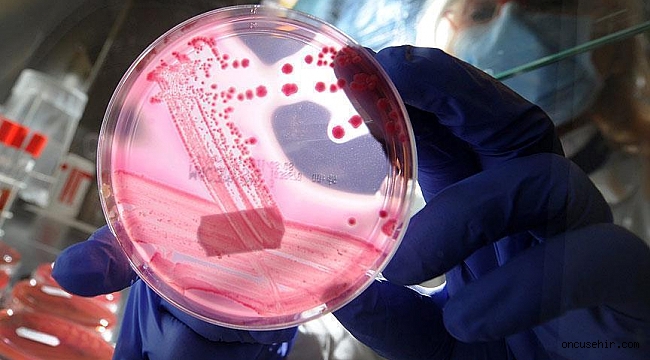

Geçmişte
test yaptıran ve yaptırmayan meme kanseri hastalarında benzer oranda gen
mutasyonları bulunduğuna ilişkin bir çalışmanın geçen aralık ayında
yayımlanmasının ardından birlik, meme kanseri teşhisi konan tüm hastalara
genetik test yapılması önerisinde bulunulan kılavuz yayımladı.
Kılavuzda
ayrıca, yeni tanımlanmış meme kanseri bağlantılı genleri kontrol etmek için
geçmişte genetik testlerden geçen meme kanseri hastalarının yeniden
değerlendirilmesi önerildi.
Herkesin
sahip olduğu tümör baskılayıcı BRCA1 ve BRCA2 genlerinin birinde veya ikisinde
bir kusur veya mutasyon meydana gelmesi halinde meme kanseri olasılığının
arttığı belirtildi.
Çalışmanın
yazarlarından Dr. Peter Beitsch, BRCA1 ve BRCA2 de dahil olmak üzere belli
başlı 11 gende mutasyonun meme kanserine yol açabileceğinin bilindiğini
söyledi.
Dr.
Beitsch, geçmişte genetik test yapmanın zor ve pahalı olduğuna işaret ederken,
Amerikan Meme Cerrahları Birliği Başkanı Dr. Walton Taylor da test yaptırma
masraflarının zaman içinde düştüğünü ifade etti.
Diğer
yandan, tüm meme kanserlerinin yüzde 10'unun kalıtsal olduğu biliniyor.